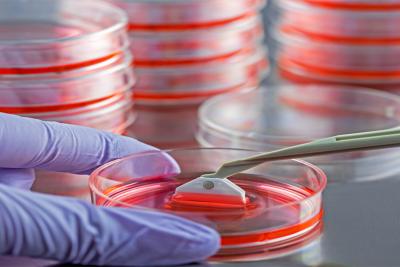
Altered States

Shawna Jackman, PhD
Cell and Gene Therapy/Phototoxicity
Cell and Gene Therapy/Phototoxicity

Shawna Jackman, PhD, DABT, is a Senior Research Scientist with the Photobiology and Cellular Therapy Safety Group at Charles River's Safety Assessment site in Horsham, Pa. She has 13 years of in vitro and in vivo experience in preclinical safety evaluation, including 11 years at Charles River’s Safety Assessment site in Horsham, Pennsylvania. In her current role, she is responsible for and is the site lead on cellular therapeutic safety regulatory interpretation along with study design, interpretation and reporting as a Study Director. Her articles have appeared in The Scientist and GEN.